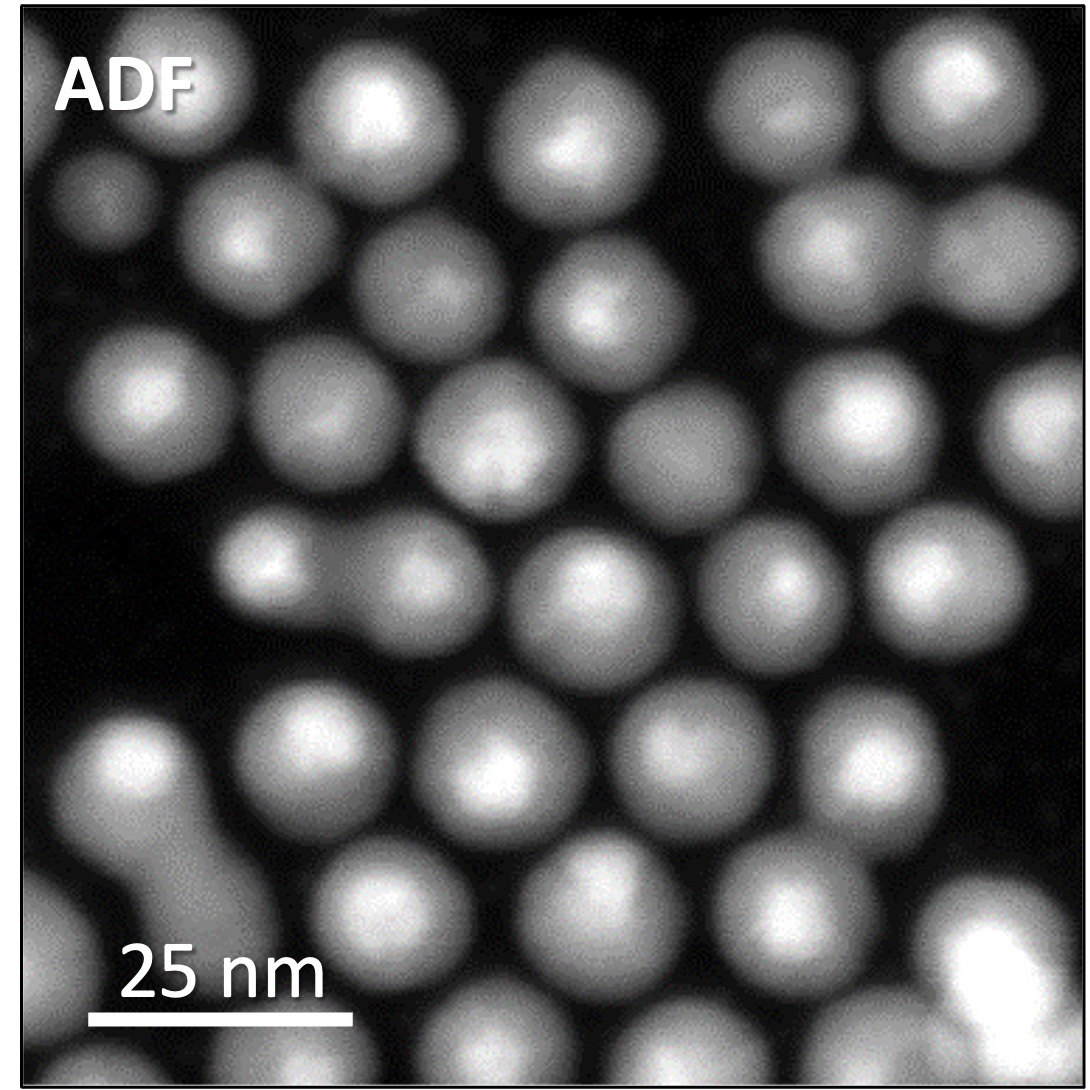
ADF
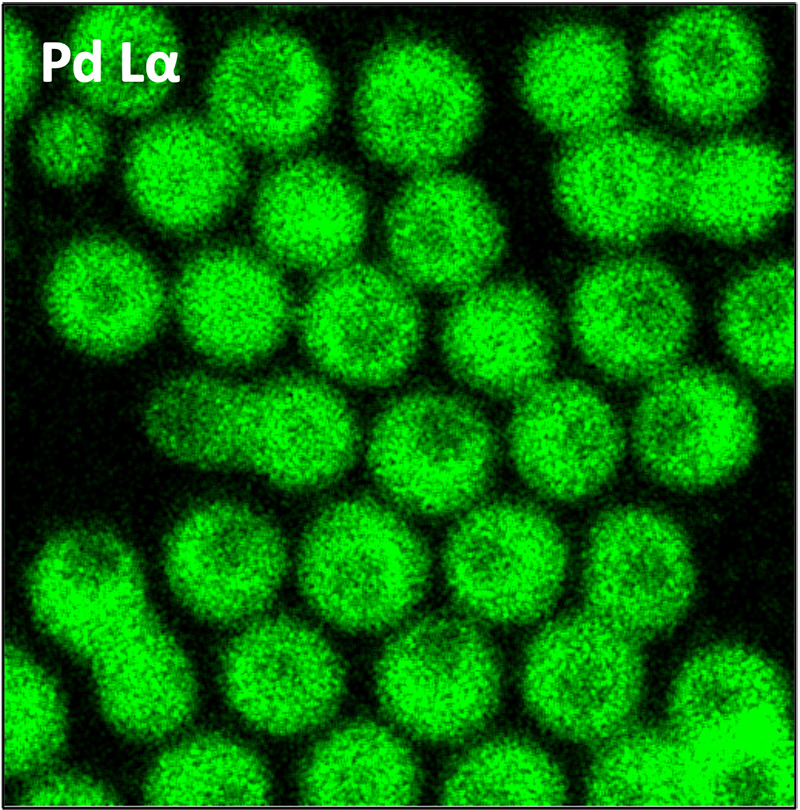
Pd Lα
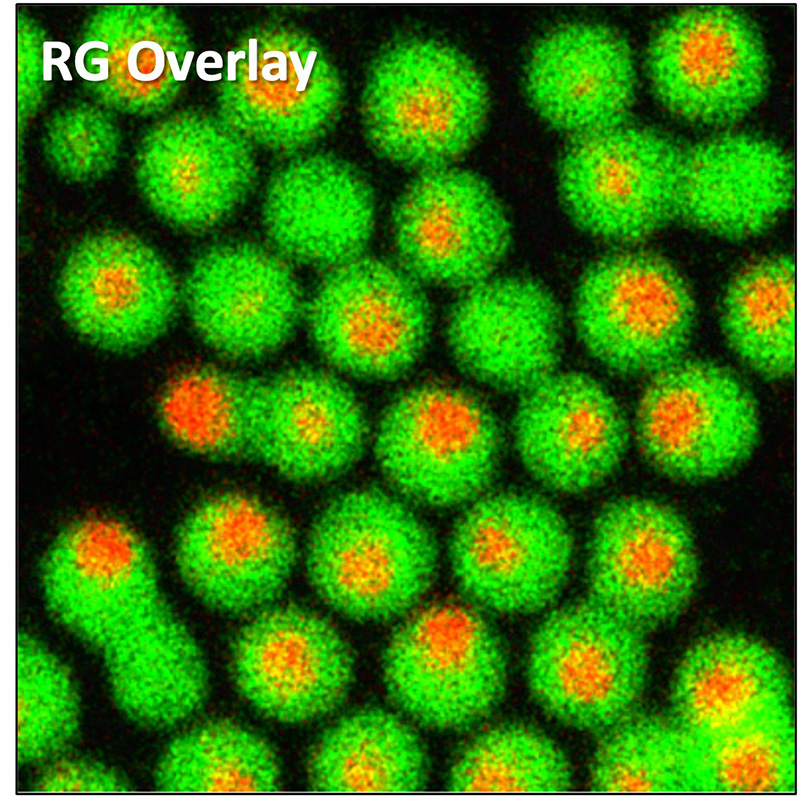
RG 叠加

天游线路检测中心 提高了空间分辨率和分析性能,配备了考虑到多用途使用的可操作性的操作系统,具有吸引从初学者到电子显微镜专家的每个人的智能外观,并且节能且二氧化碳2这是一款以降低能耗为理念而开发的场发射透射电子显微镜。
功能
视频介绍
◆点击上方方框中的播放按钮开始播放影片(约4分钟)
◆ 介绍天游线路检测中心多功能电子显微镜的特点和功能。
从高加速度到低加速度的高分辨率 TEM/STEM 观察
天游线路检测中心采用冷阴极场发射电子枪,保证高稳定性、高亮度和高能量分辨率(<033 eV),通过减少光源引起的色差,使其有效进行高分辨率观察。此外,JEOL 积累的专业知识在设计中得到了体现,机械和电气稳定性得到了极大提高,从而可以捕获漂移更少的图像。
高通量高精度EDS分析
天游线路检测中心是一款大直径(100毫米2) 可同时安装两个硅漂移探测器(SDD)(可选)。凭借更高的灵敏度,EDS 分析可以在更短的时间内进行,并且损伤更小。
高能量分辨率的 EELS 分析
天游线路检测中心 将保证高能量分辨率(<033 eV)的冷阴极场发射电子枪与 EELS(可选)相结合,可实现比肖特基场发射电子枪更详细的化学键态分析。
即使是初学者也能轻松无压力地操作。
天游线路检测中心配备了强调直观性的用户界面,并配备了TEM和STEM的自动功能,即使是初学者也能轻松操作。此外,它还配备了SPECPORTER™,即使是新手用户也可以轻松插入和移除样品支架。通过将样品支架设置在指定位置,只需一个开关即可安全地插入和移除样品支架。此外,样品台配备了 Pico 台驱动器,无需使用压电驱动机构即可以皮米级步进驱动,从而可以在宽动态范围内移动视场,从整个样品网格的视场到原子图像量级的视场。
自动功能
自动增益和偏移→自动对焦→自动污点校正
◆单击上方框中的播放按钮开始播放电影。 (40 秒)◆
无缝实现从使用 FIB 制备标本到显微镜检查的一切
双轴倾斜盒(可选)和专用 TEM 支架(可选)有助于 TEM ⇔ FIB 连接。该卡盒只需轻轻一触即可连接到专用 TEM 样品架,无需在样品制备后直接处理 TEM 网格。
与可持续发展社会兼容的透射电子显微镜
天游线路检测中心 是第一款标配 ECO 模式的透射电子显微镜。此 ECO 模式是一种节能系统,通过在设备不使用期间以最低的能耗保持设备良好状态。通过将设备置于 ECO 模式,能耗可减少至设备使用时的约 1/5,为可持续发展的社会做出贡献。它还具有计划功能,允许您在指定的日期和时间将其从 ECO 模式返回到可用状态。
规格/选项

*可移动范围可能会根据样品支架的类型以及物镜孔径的存在或不存在而变化。
使用天游线路检测中心的论文集
目录下载
申请
与天游线路检测中心相关的应用
使用通用 TEM 进行冷冻电子显微镜观察 - 从冰包埋样品制备到冷冻观察 -
岩石样品的全面无损分析工作流程 - 从元素分析到薄膜样品制备和 TEM 观察 -
使用 4D-STEM 和 STEM-EELS 进行 FinFET 的平面图观察
图库
材质:Si [110] 高分辨率 STEM

样本:Si [110]
显微镜:带 CFEG 的 天游线路检测中心 HR 极片
条件:200 kV,STEM
材质:单层MoS2表

样品:单层MoS2表
显微镜:带 CFEG 的 天游线路检测中心 HR 极片
条件:200 kV,STEM
生命科学:80 kV ABS 聚合物的 TEM 图像

样品:ABS 聚合物
显微镜:带 CFEG 的 天游线路检测中心 HR 极片
条件:80 kV,TEM
样品制备:切片机
EDS 画廊
钛酸锶

| 示例 | 钛酸锶 |
|---|---|
| 加速电压 | 200 kV |
| 地图大小 | 256 × 256 像素 |
漆膜高速EDS图








| 示例 | 漆膜 |
|---|---|
| 加速电压 | 200 kV |
| 探测电流 | 16 不适用 |
| 地图大小 | 512 × 512 像素 |
| 采集时间 | 10 秒 |
Au/Pd核壳纳米颗粒

| 示例 | Au/Pd核壳纳米颗粒 |
|---|---|
| 加速电压 | 200 kV |
| 地图大小 | 512 × 512 像素 |
示例提供者:教授。 A I 柯克兰,牛津大学博士。惠灵顿维多利亚大学的 R D Tilley 和 Anna Henning 博士
使用 EDS 断层扫描对漆膜进行三维分析

3D元素图
| 示例 | 漆膜 |
|---|---|
| 加速电压 | 200 kV |
| 倾斜角度范围 | ±68° |
| 角步 | 4° |
使用 EDS 断层扫描对半导体进行 3D 分析
2D 地图


三维元素图
示例
半导体器件
加速电压
200 kV
倾斜角度范围
±64°
角步
4°
EELS 画廊
材质:改进的冷FEG
| 示例 | 半导体器件 |
|---|---|
| 加速电压 | 200 kV |
| 倾斜角度范围 | ±64° |
| 角步 | 4° |
高亮度,小能量扩散
利用 EELS 进行碳同素异形体的化学键态分析
样品:碳同素异形体
显微镜:带 CFEG 的 天游线路检测中心 HR 极片
条件:80 kV,TEM 图像,EELS QuantumER
相关产品

SightSKY™ 系列高灵敏度/低噪声光纤耦合 CMOS 相机
配备高灵敏度、低噪声、1900 万像素 CMOS 传感器,即使在少量入射电子的情况下也能呈现样品的细节并提供清晰的图像。全局快门方法和高帧速率(58 fps/全像素模式)使得能够在动态观察期间采集抑制伪影的图像系列。它集成到集成分析平台 FEMTUS™ 中,并提供用户友好的可操作性。








